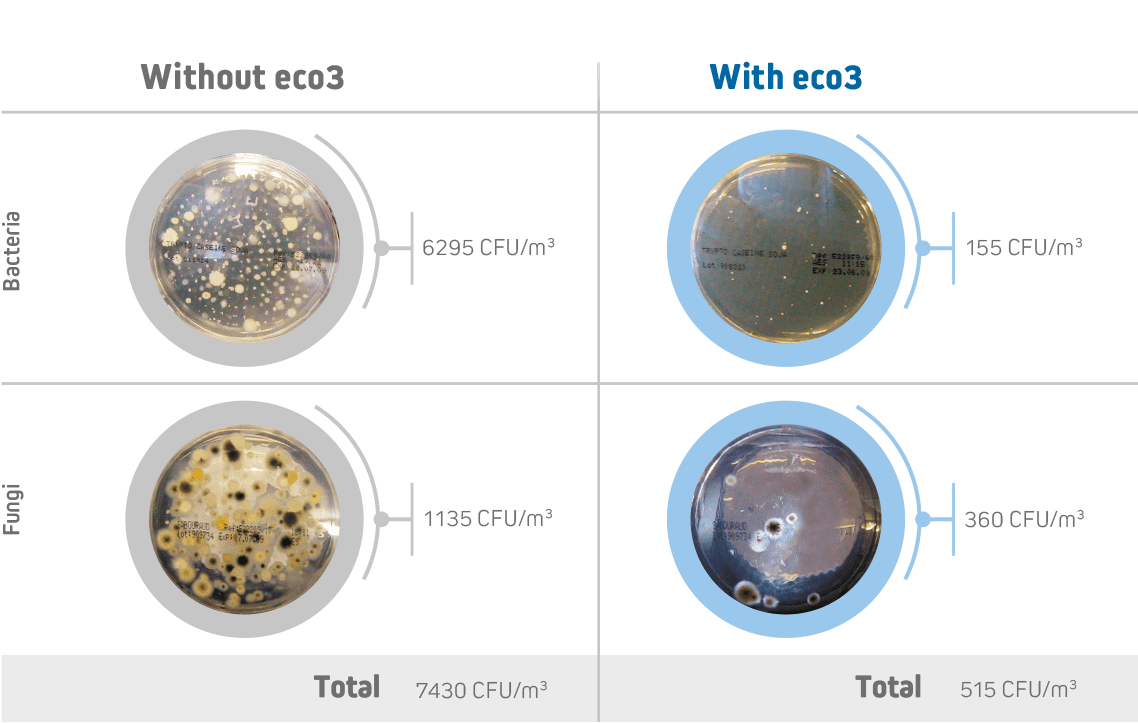

Pour améliorer la qualité de l’air dans les bus et les autocars, Hispacold a conçu l’eco3, un purificateur d’air qui élimine les virus tels que le SRAS-CoV-2, les micro-organismes, les germes et les allergènes, tout en neutralisant les mauvaises odeurs.
Cela m’intéresse* Des tests ont été réalisés par le service de défense biologique du département des systèmes de défense CBN au sein de l’Institut national de technique aérospatiale (INTA), qui dépend du ministère espagnol de la Défense, sur un autocar de 15 mètres, équipé du purificateur d’air eco3, dans lequel le virus MS2 était présent.
L’eco3, qui fonctionne en générant des ions négatifs et de l’ozone dans les proportions recommandées, augmente la concentration en oxygène dans l’air, élimine les mauvaises odeurs et maintient l’alimentation en air à des niveaux sains afin de garantir un air non vicié ni pollué.
En savoir plus Avec la collaboration de
Le purificateur d’air eco3 s’est avéré efficace dans tous les véhicules dans lesquels il a été installé. Son efficacité a été testée par SGS, un leader mondial en matière d’inspection, de vérification, de tests et de certification et testée et approuvée par le département des systèmes de défense CBN au sein de l’Institut national de technique aérospatiale (INTA), qui dépend du ministère espagnol de la Défense.
Nous contacter
* Des tests ont été réalisés par le service de défense biologique du département des systèmes de défense CBN au sein de l’Institut national de technique aérospatiale (INTA), sur un autocar de 15 mètres, équipé du purificateur d’air eco3, dans lequel le virus MS2 était présent.

L’eco3 est placé dans le système d’aspiration et de filtrage de l’unité de climatisation et commence à fonctionner automatiquement dès que le système de climatisation (climatisation, chauffage, ventilation) se met en marche. Ses avantages incluent également une consommation d’énergie négligeable.
Contrairement à d’autres dispositifs de purification et de désinfection, l’eco3 est conçu pour fonctionner au mieux lorsque les passagers sont à bord et que le véhicule est en marche. Le purificateur d’air eco3 réduit considérablement les champignons, les bactéries, les virus, les composés organiques volatils, les allergènes, etc.

Les cultures ont été prélevées sur des véhicules équipés du purificateur d’air eco3 et sur d’autres véhicules dépourvus de cet équipement. Des tests réalisés en laboratoire ont montré (sur les véhicules équipés de l’eco3) que les unités formant colonies du bactéries (UFC/m3) ont été réduites de 93 % et les unités formant plaques du virus (UFP/m3) ont été réduites de 99,7 %.
* Elle est considérée comme une flore aérobie mésophile lorsque sa température de croissance optimale est comprise entre 20 °C et 45 °C.
Conformément à la norme UNE 100012:2005, un dénombrement inférieur à 800 UFC/m3 de la flore aérobie mésophile totale* est considéré comme le dénombrement maximal recommandé pour l’air intérieur, au-delà duquel des mesures correctives sont recommandées.

Nous fournissons aux opérateurs des véhicules équipés du purificateur d’air eco3 un autocollant d’identification à coller sur leurs pare-brise.
En savoir plus
Si vous souhaitez en savoir plus ou si vous avez d’autres questions sur le purificateur d’air eco3 d’Hispacold, remplissez le bref formulaire ci-dessous, nous vous contacterons dans les plus brefs délais.
Ou contactez :
Raquel Gonzalez. directrice des ventes (responsable des ventes)
Tel.: +34 600 950 553
Proyecto: DIGIZITY - 0: INVESTIGACIÓN INDUSTRIAL DE SOLUCIONES INNOVADORAS PARA DESCARBONIZAR, DIGITALIZAR Y AUTOMATIZAR EL TRANSPORTE URBANO CON AUTOBUSES 0 EMISIONES
Acrónimo: DIGIZITY
Líder: AVANZA ZARAGOZA SAU
Socios participantes: AVANZA SPAIN, S.L., IDNEO TECHNOLOGIES, S.A., INTERNACIONAL HISPACOLD, S.A., IRIZAR, S.COOP., JEMA ENERGY, S.A. y TELNET REDES INTELIGENTES, S.A.
Organismos de Investigación: ITAINNOVA - Instituto Tecnológico de Aragón, Fundación TECNALIA Research & Innovation y CTAG - Centro Tecnolóxico de Automoción de Galicia.
Presupuesto total del proyecto: 9.094.670, 00€
Subvención otorgada: 5.440.703,35 €
Duración del proyecto: 01/11/2021 - 31/12/2023
Proyecto financiado por la Unión Europea - NextGenerationEU a través de la convocatoria para el año 2021 Programa Tecnológico de Automoción Sostenible, en el marco del Plan de Recuperación, Transformación y Resiliencia y del Programa Estatal para Catalizar la Innovación y el Liderazgo Empresarial del Plan Estatal de Investigación Científica, Técnica y de Innovación 2021-2023 promovido por el Centro para el Desarrollo Tecnológico e Industrial (CDTI)

Financiado por la Unión Europea - Next Generation EU
INTERNACIONAL HISPACOLD S.A ha participado en el proyecto tractor PERTE VEC CAPITAL (2022-2025), liderado por IRIZAR, bajo el marco del PERTE del Vehículo Eléctrico (PERTE VEC) publicado en el año 2021. Este proyecto ha sido financiado por el Ministerio de Industria, Comercio y Turismo, conforme al artículo 18 de la Ley 38/2003, de 17 de noviembre, General de Subvenciones. Además, INTERNACIONAL HISPACOLD S.A ha recibido apoyo financiero del Mecanismo de Recuperación y Resiliencia, y del Plan de Recuperación, Transformación y Resiliencia.